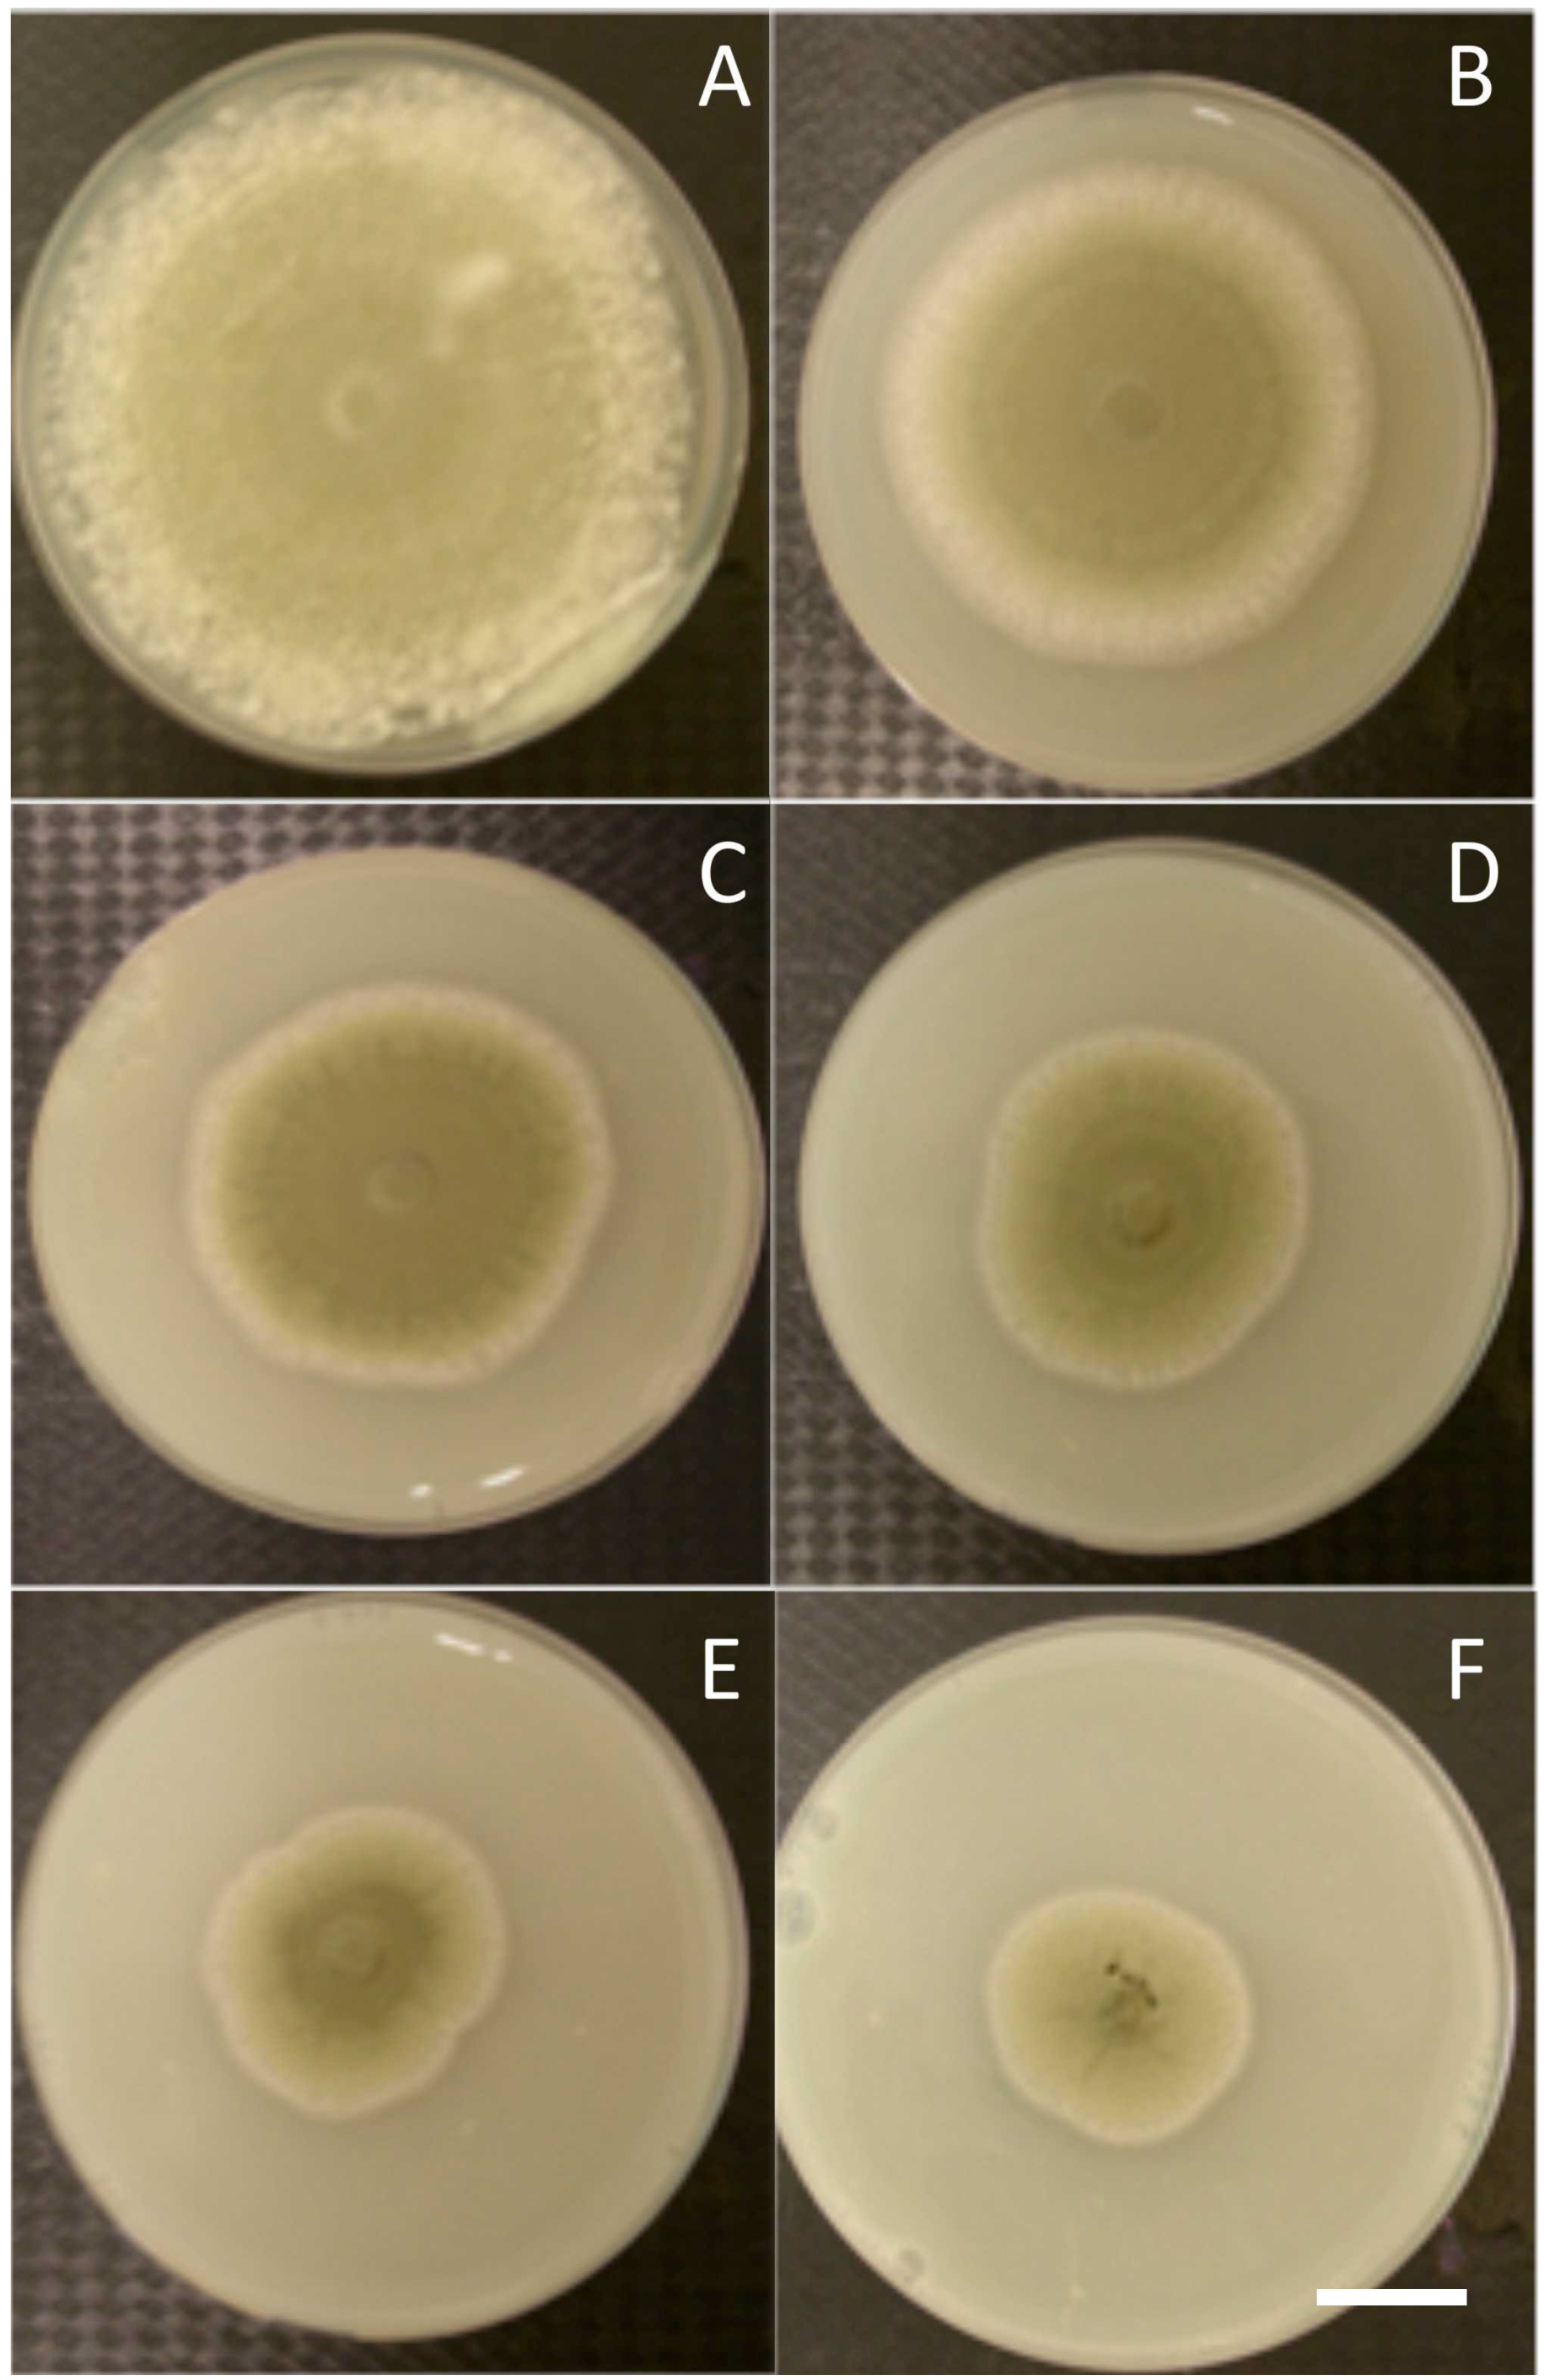

Effectiveness of Postharvest Treatment with Chitosan to Control Citrus Green Mold
Abstract
:1. Introduction
2. Materials and Methods
2.1. Fruit Treatments
2.2. Chitosan
2.3. Pathogen Inoculum
2.4. In Vitro and in Vivo Antifungal Activity of Chitosan
2.5. Anatomical Studies
2.6. Determination of Defense-Related Enzyme Activities: Chitinase and β-1,3-Glucanase
2.7. Measurement of Fruit Quality Parameters
2.8. Statistical Analyses
3. Results
3.1. In Vitro and in Vivo Antifungal Effects
3.2. Anatomical Studies
3.3. Biochemical Defense Responses
3.4. Effects on Quality Parameters of Citrus Fruits
4. Discussion
4.1. Chitosan as Antifungal
4.2. Chitosan and Postharvest Fungal Disease
4.3. Biochemical Defense as Response to Chitosan Application
4.4. Effect of Chitosan on the Postharvest Quality
5. Conclusions
Acknowledgments
Author Contributions
Conflicts of Interest
References
- Faostat, 2012. FAO Statistical Division. Available online: http://faostat3.fao.org/home/index.html (accessed on 19 December 2012).
- González-Candelas, L.; Alamar, S.; Sánchez-Torres, P.; Zacarías, L.; Marcos, J.F. A transcriptomic approach highlights induction of secondary metabolism in citrus fruit in response to Penicillium digitatum infection. BMC Plant Biol. 2010, 10, 194–211. [Google Scholar] [CrossRef] [PubMed]
- Ballester, A.R.; Izquierdo, A.; Lafuente, M.T.; González-Candelas, L. Biochemical and molecular characterization of induced resistance against Penicillium digitatum in citrus fruit. Postharvest Biol. Technol. 2010, 56, 31–38. [Google Scholar] [CrossRef]
- Cunningham, N.M.; Taverner, P.D. Efficacy of integrated postharvest treatments against mixed innoculations of Penicillium digitatum and Geotrichumcitri-aurantii in ‘leng’ navel oranges (Citrus sinensis). N. Zeal. J. Crop Hort. 2007, 35, 187–192. [Google Scholar] [CrossRef]
- Droby, S.; Eick, A.; Macarisin, D.; Cohen, L.; Rafael, G.; Stange, R.; McColum, G.; Dudai, N.; Nasser, A.; Wisniewski, M.; et al. Role of citrus volatiles in host recognition, germination and growth of Penicillium digitatum and Penicillium italicum. Postharvest Biol. Technol. 2008, 49, 386–396. [Google Scholar] [CrossRef]
- Smilanick, J.L.; Brown, G.E.; Eckert, J.W. Postharvest citrus diseases and their control. In Fresh Citrus Fruits, 2nd ed.; Wardowski, W.F., Miller, W.M., Hall, D.J., Grierson, W., Eds.; Florida Science Source, Inc.: Longboat Key, FL, USA, 2006; pp. 339–396. [Google Scholar]
- Montesinos-Herrero, C.; Smilanick, J.L.; Tebbets, J.S.; Walse, S.; Palou, L. Control of citrus postharvest decay by ammonia gas fumigation and its influence on the efficacy of the fungicide imazalil. Postharvest Biol. Technol. 2011, 59, 85–93. [Google Scholar] [CrossRef]
- Basta, N.T.; Ryan, J.A.; Chaney, R.L. Trace element chemistry in residual-treated soil: Key concepts and metal bioavailability. J. Environ. Qual. 2005, 34, 49–63. [Google Scholar] [CrossRef] [PubMed]
- Bautista-Baños, S.; Hernández-Lauzardo, A.N.; Velázquez-del Valle, M.G.; Hernández-López, M.; Ait Barka, E.; Bosquez-Molina, E.; Wilson, C.L. Chitosan as a potential natural compound to control pre and postharvest diseases of horticultural commodities. Crop Prot. 2006, 25, 108–118. [Google Scholar] [CrossRef]
- Rabea, E.I.; Badawy, M.E.; Stevens, C.V.; Smagghe, G.; Sterbault, W. Chitosan as antimicrobial agent: Application and mode of action. Biomacromolecules 2003, 4, 1457–1465. [Google Scholar] [CrossRef] [PubMed]
- Liu, J.; Tian, S.P.; Meng, X.; Xu, Y. Effects of chitosan on control of postharvest diseases and physiological responses of tomato fruit. Postharvest Biol. Technol. 2007, 44, 300–306. [Google Scholar] [CrossRef]
- El Hadrami, A.; El Hadrami, I.; Daayf, F. Suppression of induced plant defense responses byfungal pathogens. In Molecular Plant-Microbe Interaction; Bouarab, K., Brisson, N., Daayf, F., Eds.; CABI: Wallingford, UK, 2009; pp. 231–268. [Google Scholar]
- Jayaraj, J.; Rahman, M.; Wan, A.; Punja, Z.K. Enhanced resistance to foliar fungal pathogens in carrot by application of elicitors. Ann. Appl. Biol. 2009, 155, 71–80. [Google Scholar] [CrossRef]
- Nandeeshkumar, P.; Sudisha, J.; Ramachandra, K.K.; Prakash, H.S.; Niranjana, S.R.; Shekar, S.H. Chitosan induced resistance to downy mildew in sunflower caused by Plasmopara halstedii. Physiol. Mol. Plant Path. 2008, 72, 188–194. [Google Scholar] [CrossRef]
- Romanazzi, G.; Lichter, A.; Gabler, F.M.; Smilanick, J. Natural and safe alternatives to conventional methods to control postharvest gray mold of table grapes. Postharvest Biol. Technol. 2012, 63, 141–147. [Google Scholar] [CrossRef]
- Ait Barka, E.; Nowak, J.; Christophe, C. Enhancement of chilling resistance of inoculated grapevine plantlets with a plant growth-promoting rhizobacterium, Burkholderia phytofirmans strain PsJN. Appl. Environ. Microbiol. 2006, 72, 7246–7252. [Google Scholar] [CrossRef] [PubMed]
- Yao, H.; Tian, S. Effects of pre- and post-harvest application of salicylic acid or methyl jasmonate on inducing disease resistance of sweet cherry fruit in storage. Postharvest Biol. Technol. 2005, 35, 253–262. [Google Scholar] [CrossRef]
- Wirth, S.A.; Wolf, G.A. Dye-labelled substrates for the assay and detection of chitinase and lysozyme activity. J. Microbiol. Meth. 1990, 11, 197–205. [Google Scholar] [CrossRef]
- Bradford, M.M. A rapid and sensitive method for the quantitation of microgram quantities of protein utilizing the principle of protein-dye binding. Anal. Biochem. 1976, 72, 248–254. [Google Scholar] [CrossRef]
- AOAC. Official Methods of Analysis, 17th ed.; Association of Analytical Chemists International: Washington, DC, USA, 1995. [Google Scholar]
- Romanazzi, G.; Murolo, S.; Feliziani, E. Effects of an innovative strategy to contain grapevine Bois noir: Field treatment with resistance inducers. Phytopathology 2013, 103, 785–791. [Google Scholar] [CrossRef] [PubMed]
- Yin, H.; Zhao, X.; Du, Y. Oligochitosan: A plant diseases vaccine—A review. Carbohydr. Polym. 2010, 82, 1–8. [Google Scholar] [CrossRef]
- Zhang, H.; Li, R.; Liu, W. Effects of chitin and its derivative chitosan on postharvest decay of fruits: A review. Int. Mol. Sci. 2011, 12, 917–934. [Google Scholar] [CrossRef] [PubMed]
- Ait Barka, E.; Eullaffroy, P.; Clément, C.; Vernet, G. Chitosan improves development, and protects Vitis vinifera L. against Botrytis cinerea. Plant Cell Rep. 2004, 22, 608–614. [Google Scholar] [CrossRef] [PubMed]
- Ali, A.; Zahid, N.; Manickam, S.; Siddiqui, Y.; Alderson, P.G.; Maqbool, M. Induction of lignin and pathogenesis related proteins in dragon fruit plants in response to submicron chitosan dispersions. Crop Prot. 2014, 63, 83–88. [Google Scholar] [CrossRef]
- Chen, J.; Zou, X.; Liu, Q.; Wang, F.; Feng, W.; Wan, N. Combination effect of chitosan and methyl jasmonate on controlling Alternaria alternata and enhancing activity of cherry tomato fruit defense mechanisms. Crop Protection 2014, 56, 31–36. [Google Scholar] [CrossRef]
- Heng, Y.; Yan, L.; Zhang, H.Y.; Wang, W.X.; Lu, H.; Grevsen, K.; Zhao, X.; Du, Y. Chitosan oligosaccharides-triggered innate immunity contributes to oilseed rape resistance against Sclerotinia sclerotiorum. Int. J. Plant Sci. 2013, 174, 722–732. [Google Scholar]
- Avadi, M.R.; Jalali, A.; Sadeghi, A.M.; Shamimi, K.; Bayati, K.H.; Nahid, E.; Dehpour, A.R.; RafieeTehrani, M. Diethyl methyl chitosan as an intestinal paracellular enhancer: Ex vivo and in vivo studies. Int. J. Pharm. 2005, 293, 83–89. [Google Scholar] [CrossRef] [PubMed]
- Boller, T.; Felix, G. A renaissance of elicitors: Perception of microbe-associated molecular patterns and danger signals by pattern-recognition receptors. Ann. Rev. Plant Biol. 2009, 60, 379–406. [Google Scholar] [CrossRef] [PubMed]
- Chien, P.J.; Chou, C.C. Antifungal activity of chitosan and its application to control postharvest quality and fungal rotting of Tankan citrus fruit (Citrus tankan Hayata). J. Sci. Food Agric. 2006, 86, 1964–1969. [Google Scholar] [CrossRef]
- Chien, P.J.; Sheu, F.; Lin, H.R. Coating citrus (Murcott tangor) fruit with low molecular weight chitosan increases postharvest quality and shelf life. Food Chem. 2007, 100, 1160–1164. [Google Scholar] [CrossRef]
- Long, L.T.; Tien, N.T.T.; Trang, N.H.; Ha, T.T.T.; Hieu, N.M. Study on Antifungal Ability of Water Soluble Chitosan against Green Mould Infection in Harvested Oranges. J. Agric. Sci. 2014, 6, 205. [Google Scholar] [CrossRef]
- Li, Y.C.; Sun, X.J.; Bi, Y.; Ge, Y.H.; Wang, Y. Antifungal activity of chitosan on Fusarium sulphureum in relation to dry rot of potato tuber. Agric. Sci. China 2009, 8, 597–604. [Google Scholar] [CrossRef]
- Perdones, A.; Sánchez-González, L.; Chiralt, A.; Vargas, M. Effect of chitosan–lemon essential oil coatings on storage-keeping quality of strawberry. Postharvest Biol. Technol. 2012, 70, 32–41. [Google Scholar] [CrossRef]
- Ramos-García, M.; Bosquez-Molina, E.; Hernández-Romano, J.; Zavala-Padilla, G.; Terrés-Rojas, E.; Alia-Tejacal, I.; Barrera-Necha, L.; Hernández-López, M.; Bautista-Baños, S. Use of chitosanbased edible coatings in combination with other natural compounds, to control Rhizopus stolonifer and Escherichia coli DH5α in fresh tomatoes. Crop Prot. 2012, 38, 1–6. [Google Scholar] [CrossRef]
- Benhamou, N.; Kloepper, J.W.; Tuzun., S. Induction of resistance against Fusarium wilt of tomato by combination of chitosan with an endophytic bacterial strain: Ultrastructure and cytochemistry of the host response. Planta 1998, 204, 153–168. [Google Scholar] [CrossRef]
- Szandala, E.S.; Backhouse, D. Effect of sporulation of Botrytis cinerea by antagonists applied after infection. Australas. Plant Pathol. 2001, 30, 165–170. [Google Scholar] [CrossRef]
- Van Loon, L.C.; Bakker, P.A.H.M. Signalling in Rhizobacteria-Plant Interactions. In Root ecology (Ecological Studies); De Kroon, J., Visser, E.J.W., Eds.; Springer Verlag: Berlin, Gremany, 2004; Vol. 168, pp. 287–330. [Google Scholar]
- Shibuya, N.; Minami, E. Oligosaccharide signalling for defence responses in plant. Physiol. Mol. Plant Pathol. 2001, 59, 223–233. [Google Scholar] [CrossRef]
- Zhang, D.; Quantick, P.C. Antifungal effects of chitosan coating on fresh strawberries and raspberries during storage. J. Hort. Sci. Biotechnol. 1998, 73, 763–767. [Google Scholar] [CrossRef]
- Ji, C.; Kuc, J. Purification and characterization of an acidic beta-1,3-glucanase from cucumber and its relationship to systemic disease resistance induced by Colletotrichum lagenarium and tobacco necrosis virus. Mol. Plant Microbe Interact. 1995, 8, 899–905. [Google Scholar] [CrossRef] [PubMed]
- Barkai-Golan, R. Postharvest Diseases of Fruits and Vegetables: Development and Control; Elsevier: Philadelphia, PA, USA, 2001. [Google Scholar]
- Fajardo, J.E.; McCollum, T.G.; McDonald, R.E.; Mayer., R.T. Differential induction of proteins in orange flavedo by biologically based elicitors and challenged by Penicillium digitatum Sacc. Biol. Control 1998, 13, 143–151. [Google Scholar] [CrossRef]
- Rodov, V.; Agar, T.; Peretz, J.; Nafussi, B.; Kim, J.J.; Ben-Yehoshua, S. Effect of combined application of heat treatments and plastic packaging on keeping quality of ‘Oroblanco’ fruit (Citrus grandis L. x C. paradisi Macf.). Postharvest Biol. Technol. 2000, 20, 287–294. [Google Scholar] [CrossRef]
- Burdon, J.N.; Dori, S.; Lomaniec, E.; Marinansky, R.; Pesis, E. The post-harvest ripening of water stressed banana fruits. J. Hortic. Sci. 1994, 69, 799–804. [Google Scholar] [CrossRef]
- Baldwin, E.A. Edible coatings for fresh fruits and vegetables, past, present, and future. In Edible Coatings and Films to Improve Food Quality; Krochta, J.M., Baldwin, E.A., Nisperos-Carriedo, M.O., Eds.; Technomic Publishing Co.: Lancaster, PA, USA, 1994; pp. 25–64. [Google Scholar]
- Obenland, D.; Collin, S.; Sievert, J.; Fjeld, K.; Doctor, J.; Arpaia, M.L. Commercial packing and storage of navel oranges alters aroma volatiles and reduces flavor quality. Postharvest Biol. Technol. 2008, 47, 159–167. [Google Scholar] [CrossRef]
- Togrul, H.; Arslan, N. Carboxymethyl cellulose from sugar beet pulp cellulose as a hydrophilic polymer in coating of mandarin. J. Food Eng. 2004, 62, 271–279. [Google Scholar] [CrossRef]
- Jiang, Y.; Li, Y. Effects of chitosan coating on postharvest life and quality of longan fruit. Food Chem. 2001, 73, 139–143. [Google Scholar] [CrossRef]
- Li, H.; Yu, T. Effect of chitosan on incidence of brown rot, quality and physiological attributes of postharvest peach fruit. J. Sci. Food Agric. 2000, 81, 269–274. [Google Scholar] [CrossRef]
- Srinivasa, P.C.; Baskaran, R.; Armes, M.N.; Harish Prashanth, K.V.; Tharanathan, R.N. Storage studies of mango packed using biodegradable chitosan film. Eur. Food Res. Technol. 2002, 215, 504–508. [Google Scholar]
- Gol, N.B.; Patel, P.R.; Ramana Rao, T.V. Improvement of quality and shelf-life of strawberries with edible coatings enriched with chitosan. Postharvest Biol. Technol. 2013, 85, 185–195. [Google Scholar] [CrossRef]
- Bautista-Baños, S.; Hernández-López, M.; Bosquez-Molina, E. Growth inhibition of selected fungi by chitosan and plant extracts. Mexican J. Phytopathol. 2004, 22, 178–186. [Google Scholar]

© 2016 by the authors; licensee MDPI, Basel, Switzerland. This article is an open access article distributed under the terms and conditions of the Creative Commons by Attribution (CC-BY) license (http://creativecommons.org/licenses/by/4.0/).
Share and Cite
El Guilli, M.; Hamza, A.; Clément, C.; Ibriz, M.; Ait Barka, E. Effectiveness of Postharvest Treatment with Chitosan to Control Citrus Green Mold. Agriculture 2016, 6, 12. https://doi.org/10.3390/agriculture6020012
El Guilli M, Hamza A, Clément C, Ibriz M, Ait Barka E. Effectiveness of Postharvest Treatment with Chitosan to Control Citrus Green Mold. Agriculture. 2016; 6(2):12. https://doi.org/10.3390/agriculture6020012
Chicago/Turabian StyleEl Guilli, Mohammed, Abdelkhak Hamza, Christophe Clément, Mohammed Ibriz, and Essaid Ait Barka. 2016. "Effectiveness of Postharvest Treatment with Chitosan to Control Citrus Green Mold" Agriculture 6, no. 2: 12. https://doi.org/10.3390/agriculture6020012
APA StyleEl Guilli, M., Hamza, A., Clément, C., Ibriz, M., & Ait Barka, E. (2016). Effectiveness of Postharvest Treatment with Chitosan to Control Citrus Green Mold. Agriculture, 6(2), 12. https://doi.org/10.3390/agriculture6020012

